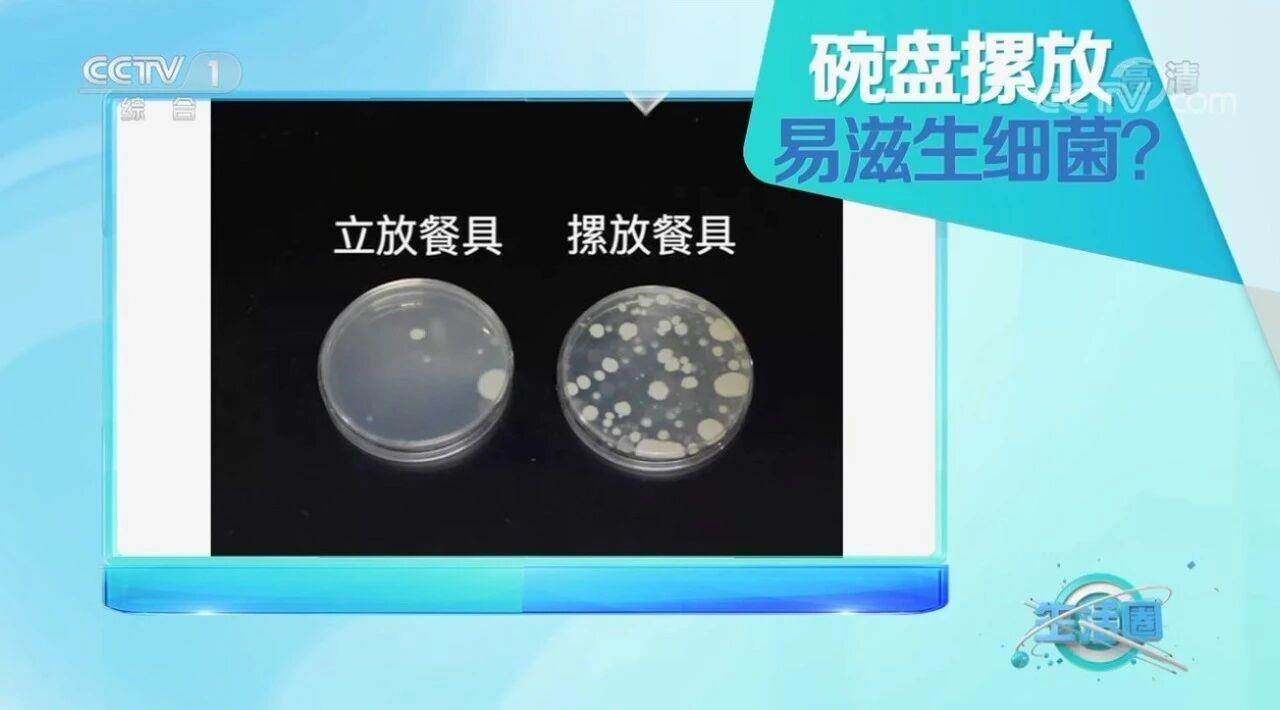

洗碗海綿這樣用可能比馬桶圈還臟 3個洗碗誤區要避免
洗碗這項看似簡單的活兒
其實包含不少“技術含量”
3個常見的洗碗誤區:
不定期更換洗碗海綿
清洗后的餐具摞著放
洗潔精直接抹在碗上
你中了幾個?
洗碗海綿這樣用
可能比你家馬桶圈還臟
2017年,發表在《自然》雜志上的一項研究顯示,一塊長期使用的洗碗海綿上,每立方厘米的細菌數高達540億個,整塊海綿的細菌種類可以高達362種。所以不夸張地說,洗碗海綿可能比你家的馬桶圈還要臟,這可能與以下3點有關。
洗碗海綿的特殊結構
海綿疏松多孔,有很多大小不一的孔洞,這些孔洞中會“藏”著水分、食物殘渣和油污,為細菌滋生提供適宜條件。注意:即使是“看起來干凈”的洗碗海綿,也可能會滋生細菌。
洗碗海綿常處于濕潤狀態
洗碗海綿在洗完碗后,即使不滴水了,也常處于濕潤狀態,無法立馬、徹底變干燥,為藏在海綿里的細菌提供了適宜滋生的環境。
洗碗海綿是個“細菌收集器”
洗碗海綿常用于清潔不同物品,比如切過生肉的案板、油膩的炒鍋、殘留食物殘渣的碗盤等,這些物品上不同的細菌最終聚集在洗碗海綿上,使洗碗海綿上的細菌異常豐富。
洗碗海綿的使用方法:
洗碗海綿用完后及時清洗干凈,擠干水分,放置在干燥、通風處。
最好每2周更換一次洗碗海綿。
除了洗碗海綿,廚房里還有另一個容易被忽略的物品——擦碗布。
碗盤清洗過后,表面可能會有一些積水,直接放進櫥柜里,可能會把櫥柜弄濕,還可能會滋生細菌。所以很多人都喜歡用擦碗布,把碗盤擦干后再收納起來。但看似干凈的擦碗布,用的時間長了,每天還濕漉漉的,可能同樣會滋生細菌。
擦碗布的使用方法:
擦碗布用完后要及時晾干并定期高溫消毒。
最好每個月更換一次擦碗布。
擦碗布最好專門用來擦碗,不要有其他用途,比如擦飯桌、擦灶臺等。
餐具最好不要摞著放
有的人覺得擦碗布用起來麻煩,那么清洗過后的餐具,直接摞著收納起來是否可以呢?這樣做也是不衛生的!
營養物質、適宜的溫度、水分是細菌滋生的必要條件。如果清洗后的碗盤中積了很多水,又有一些細小的食物殘渣,此時直接把碗盤摞在一起,房間溫度又適宜,細菌可能就會“瘋長”。
一組試驗曾顯示,摞著放的餐具細菌數量約為立著放的餐具的70倍。
短期內急性影響:滋生致病菌,比如大腸桿菌、沙門氏菌、諾如病毒、輪狀病毒等,這些致病菌可能會造成急性胃腸炎,上吐下瀉甚至脫水、休克,危及生命。
長期影響:滋生霉菌,比如黃曲霉毒素這樣的一類致癌物,長期接觸可能會致癌,另外餐具也是幽門螺桿菌傳播的媒介,胃病、胃潰瘍甚至胃癌都與幽門螺桿菌有一定關系。
碗盤存放的正確做法:
洗完的碗盤應該立起來存放在通風處,這樣殘留的水分容易瀝干,即使有一點食物殘渣,也不容易滋生細菌。
條件允許的情況下,也可以買一個消毒機,把餐具專門放在里面高溫消毒。
洗潔精別直接擠在
洗碗海綿和碗上
有人覺得“洗潔精直接抹在碗上或者擠在洗碗海綿上,去油污效果更強”。但這樣洗碗,容易使洗潔精殘留在餐具上,不僅浪費水,殘留的化學物質還有可能會被吃進肚子里,引發腹瀉等腸道不適。
洗碗的正確方法:
清除食物殘渣:吃完飯后立即倒掉食物殘渣,也可以用廚房紙巾擦去表面油脂,減少后續清洗難度。
使用洗潔精對餐具進行清洗:將洗潔精倒入水中,攪拌均勻,然后用洗碗海綿蘸著洗潔精水清洗餐具,洗干凈后再用清水將餐具沖洗干凈。
正確存放清洗過的餐具:將洗過的餐具立起來存放在通風處,瀝干水分。
來源:央視一套
編輯:張寧